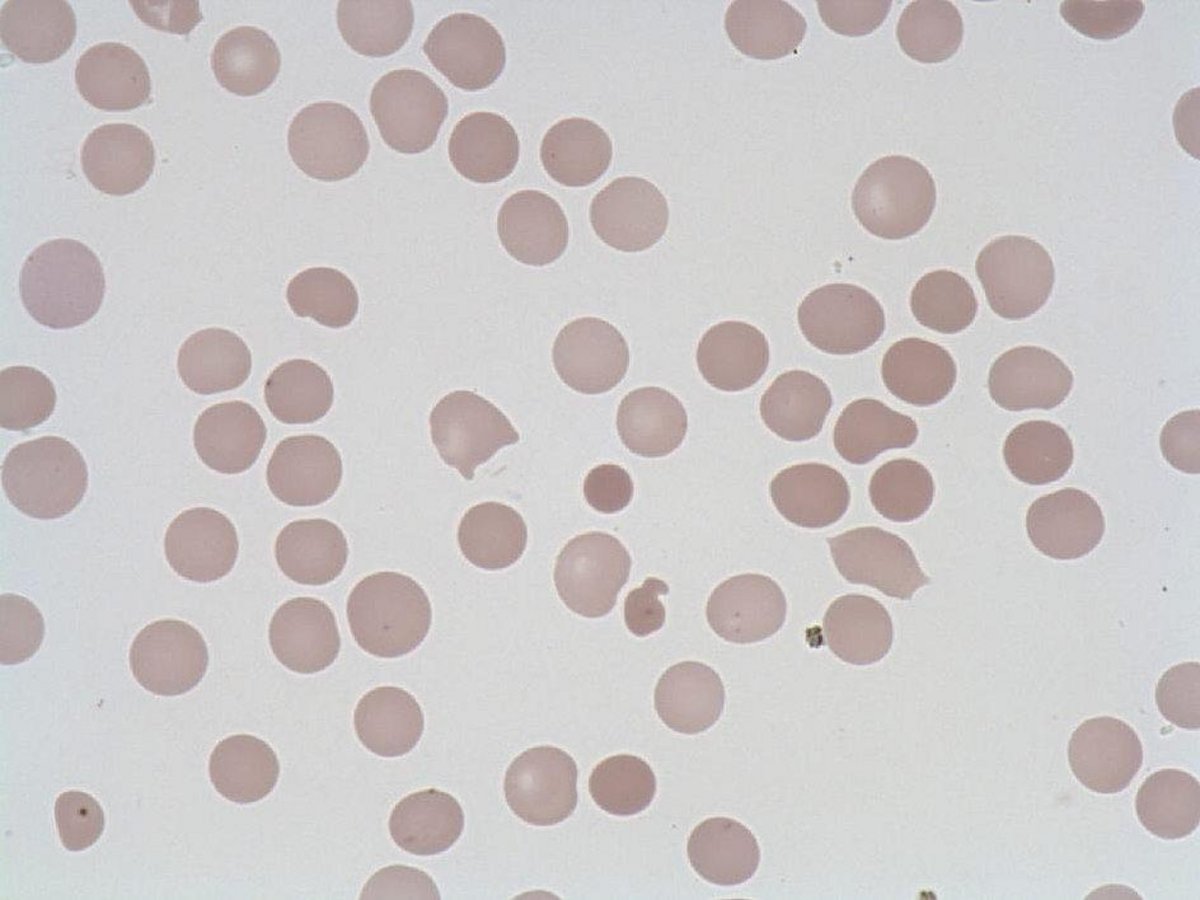
Spherocyte

Spherocyte
- Size : < 1 RBC
- Normal values : Absent in the blood
- Description / Pathology :
Very dense, spherical RBC, sometimes with small loss of central clear zone.
Membrane abnormalities (e.g. Minkowski-Chauffard disease). Hemolytic anemia.
Very dense, spherical RBC, sometimes with small loss of central clear zone.
Membrane abnormalities (e.g. Minkowski-Chauffard disease). Hemolytic anemia.